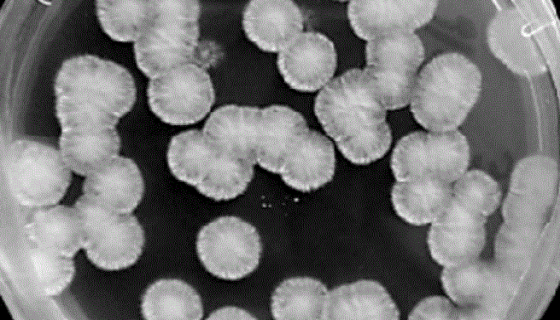
白地霉的形态特征与生长习性及奶酪中的研究进展！

EA.hy926(人脐静脉细胞融合细胞)的注意事项!
EA.hy926细胞是在PEG胁迫下,将原代培养的人脐静脉细...

鼠伤寒沙门菌的生化特征与临床表现及治疗与预防!
鼠伤寒沙门菌(S.typhimurium)属多价O抗血清的B...

肠道有害菌——脱硫弧菌属(Desulfovibrio)
脱硫弧菌,也被称为硫酸盐还原菌(SRB)属于变形菌门。这类细...
白地霉的形态特征与生长习性及奶酪中的研究进展!
白地霉的形态特征介于酵母菌和霉菌之间,繁殖方式以裂殖为主,少...

芽孢杆菌属的形态特征与生理特性及分布范围!
芽孢杆菌属是芽孢杆菌科的1属革兰氏染色阳性菌。产生芽孢,需氧...

小鼠肾足细胞的培养步骤与处理方法及应用!
小鼠肾足细胞分离自小鼠肾脏的上皮细胞样的贴壁原代细胞细胞系,...

大肠杆菌菌株的分类与区别及在生物技术中的应用!
大肠杆菌(Escherichia coli)大肠埃希氏菌,它...

幽门螺旋杆菌可引起多种疾病,要预防家庭内传播!
幽门螺旋杆菌是一种螺旋状、微需氧菌,是目前所知能在人体胃内强...

具核梭杆菌——大肠癌犯罪嫌疑菌!
具核梭杆菌,革兰氏阳性无芽孢专性厌氧菌,两端尖锐,中间膨大,...